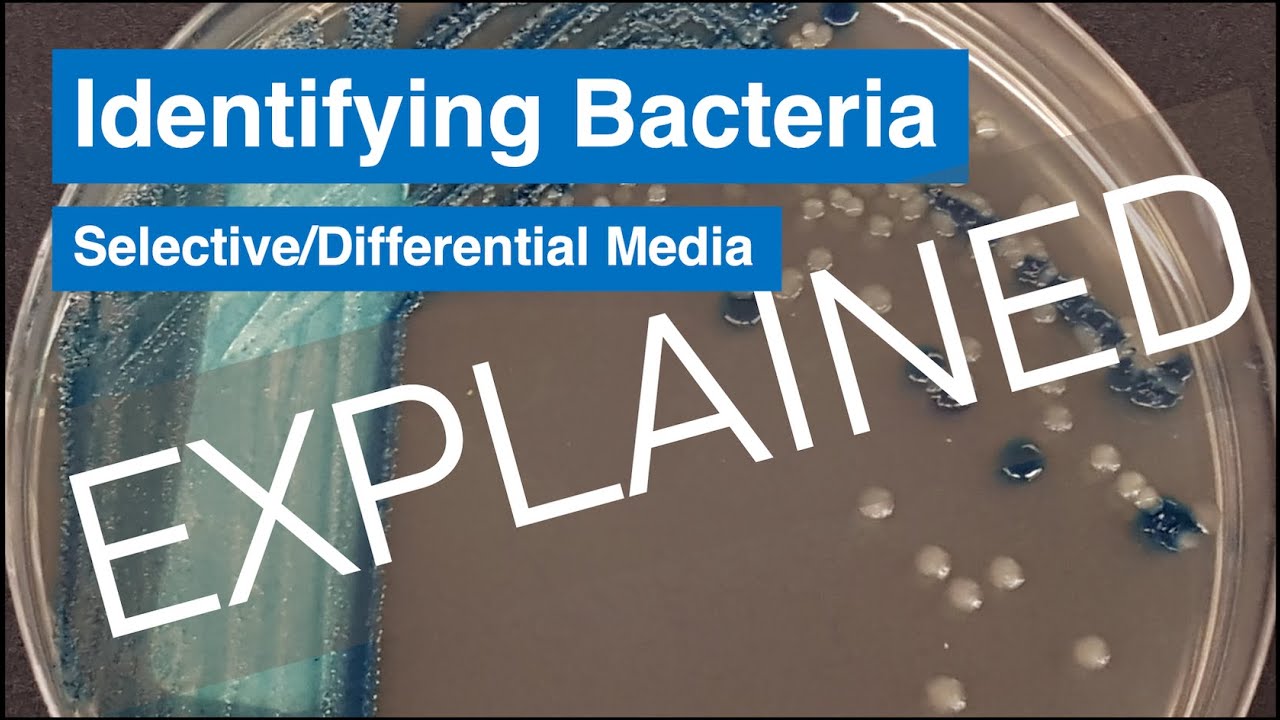
Селективный и дифференциальный агар — пояснения!

How to Identify Haemophilus influenzae in a Sputum Culture
Автор: Suzanne Clark
Загружено: 2015-11-17
Просмотров: 16449
This is an educational video to help clinical microbiology lab students work through a sputum culture with potential Haemophilus influenzae. This on-line resource presentation was submitted as assignment #4 in PIDP 3240.

Доступные форматы для скачивания:
Скачать видео mp4
-
Информация по загрузке: